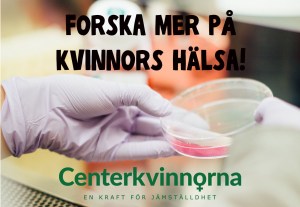

Om du är kvinna eller man påverkar den medicinska behandling och det bemötande du får i vården. Vi anser att det är helt oacceptabelt. Mer resurser måste läggas på forskning på kvinnor och på de sjukdomar som bara drabbar kvinnor. Centerkvinnorna i Göteborg kräver därför, på internationella kvinnodagen den 8 mars 2020, att mer resurser läggs på forskning på kvinnor och på de sjukdomar som bara drabbar kvinnor.
Den 3 mars hade Centerkvinnorna i Göteborg årsmöte. Under årsmötet valdes styrelsen för det nya verksamhetsåret med Karin Östring Bergman i spetsen som ordförande. Årsmötet beslöt även att kvinnors hälsa ska vara en fokusfråga.
På partistämman 2019 antog Centerpartiet program för trygg kvinnohälsovård genom hela livet. Vi vill att Centerpartiet tar ytterligare steg för jämställd hälsa och verkar för ökade anslag till forskning på kvinnor och på de sjukdomar som bara drabbar kvinnor. För idag är kvinnosjukdomar lågprioriterade inom forskningen enligt Centrum för genusmedicin på Karolinska Institutet.
Hjärt- och kärlsjukdomar drabbar båda könen i lika stor utsträckning, men kvinnor saknas ofta i de studier som görs. En ny forskningsrapport visar att risken att avlida i hjärtinfarkt är två gånger högre för kvinnor som drabbas än den är för män. Studien är ett samarbete mellan Danderyds sjukhus, Karolinska Institutet och University of Leeds. Den ojämställda vården pekas ut som en trolig orsak till skillnaderna i dödlighet. Kvinnor och män reagerar olika på medicinsk behandling. Forskning på kvinnor och jämställd vård skulle kunna rädda liv.
Ju mer forskning desto mer kunskap och på sikt bättre behandlingsmetoder. Ett exempel på det är den studie som Karolinska universitetssjukhuset i Huddinge har påbörjat för att kartlägga hur ett friskt underliv ser ut. Det görs för att kvinnor som har drabbats av förlossningsskador ska kunna få korrekt diagnos och rätt behandling. Ett annat exempel är att Svensk Kirurgisk förening just nu håller på att arbeta fram nationella riktlinjer för behandling av delade magmuskler efter graviditet, sedan det har gjorts en sammanställning av hur livskvaliteten förbättras för de kvinnor som opereras. Det är ett ingrepp som i dag inte beviljas av alla regioner – bara ytterligare ett exempel på den ojämställda och ojämlika vården. Mer forskningsanslag behövs till sjukdomar som bara drabbar kvinnor, till exempel de som är kopplade till fertilitet och förlossning.
Centerkvinnorna anser att det är helt oacceptabelt att ditt kön styr vilka möjligheter du har att få en god vård. Forskning och tester av nya behandlingsformer och läkemedel bör göras på kvinnor i olika åldrar, i samma utsträckning som på män. Kunskap som bygger på ny forskning om kvinnors hälsa och om de sjukdomar som enbart drabbar kvinnor behöver sammanställas, spridas och implementeras inom vården i hela landet för att finnas nära patienterna.
Forskning på sjukdomar som drabbar kvinnor är ett forskningsområde som är eftersatt. Det är hög tid att agera med politisk handlingskraft och riktade medel till ett nationellt forskningsprogram så att vi säkerställer en jämställd vård. Därför driver vi Centerkvinnor i Göteborg frågan om ökade anslag till forskning om kvinnors hälsa.

En reaktion till “Vi kräver forskningsprogram på kvinnosjukdomar”
Kommentarer är stängda.